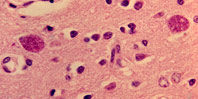
Заражение паразитами заставляет людей идти на риск

Ранее уже было показано, как заражение меняет поведение грызунов — они перестают бояться кошек. Вероятно, нечто похожее происходит и с людьми. Группа ученых проверила наличие паразита у 1495 студентов. Те, у кого их нашли, в 1,4 раза чаще учились на факультетах, связанных с управлением и бизнесом, и в 1,7 раз чаще выбирали в качестве специализации менеджмент и предпринимательство. Не зараженные студенты чаще учились на факультетах наук (физики, химики, биологи) и искусств.
Аналогичная проверка была проведена в отношении 197 участников семинаров для предпринимателей. Зараженные в 1,8 раз чаще открывали собственный бизнес. А анализ показателей заражения в 42 странах выявил: жители государств, где паразит встречался чаще, были более склонны к предпринимательской деятельности. По словам ученых, паразит может усиливать склонность к рискованному поведению. А предпринимательство требует готовности к риску.
материал с сайта www.meddaily.ru